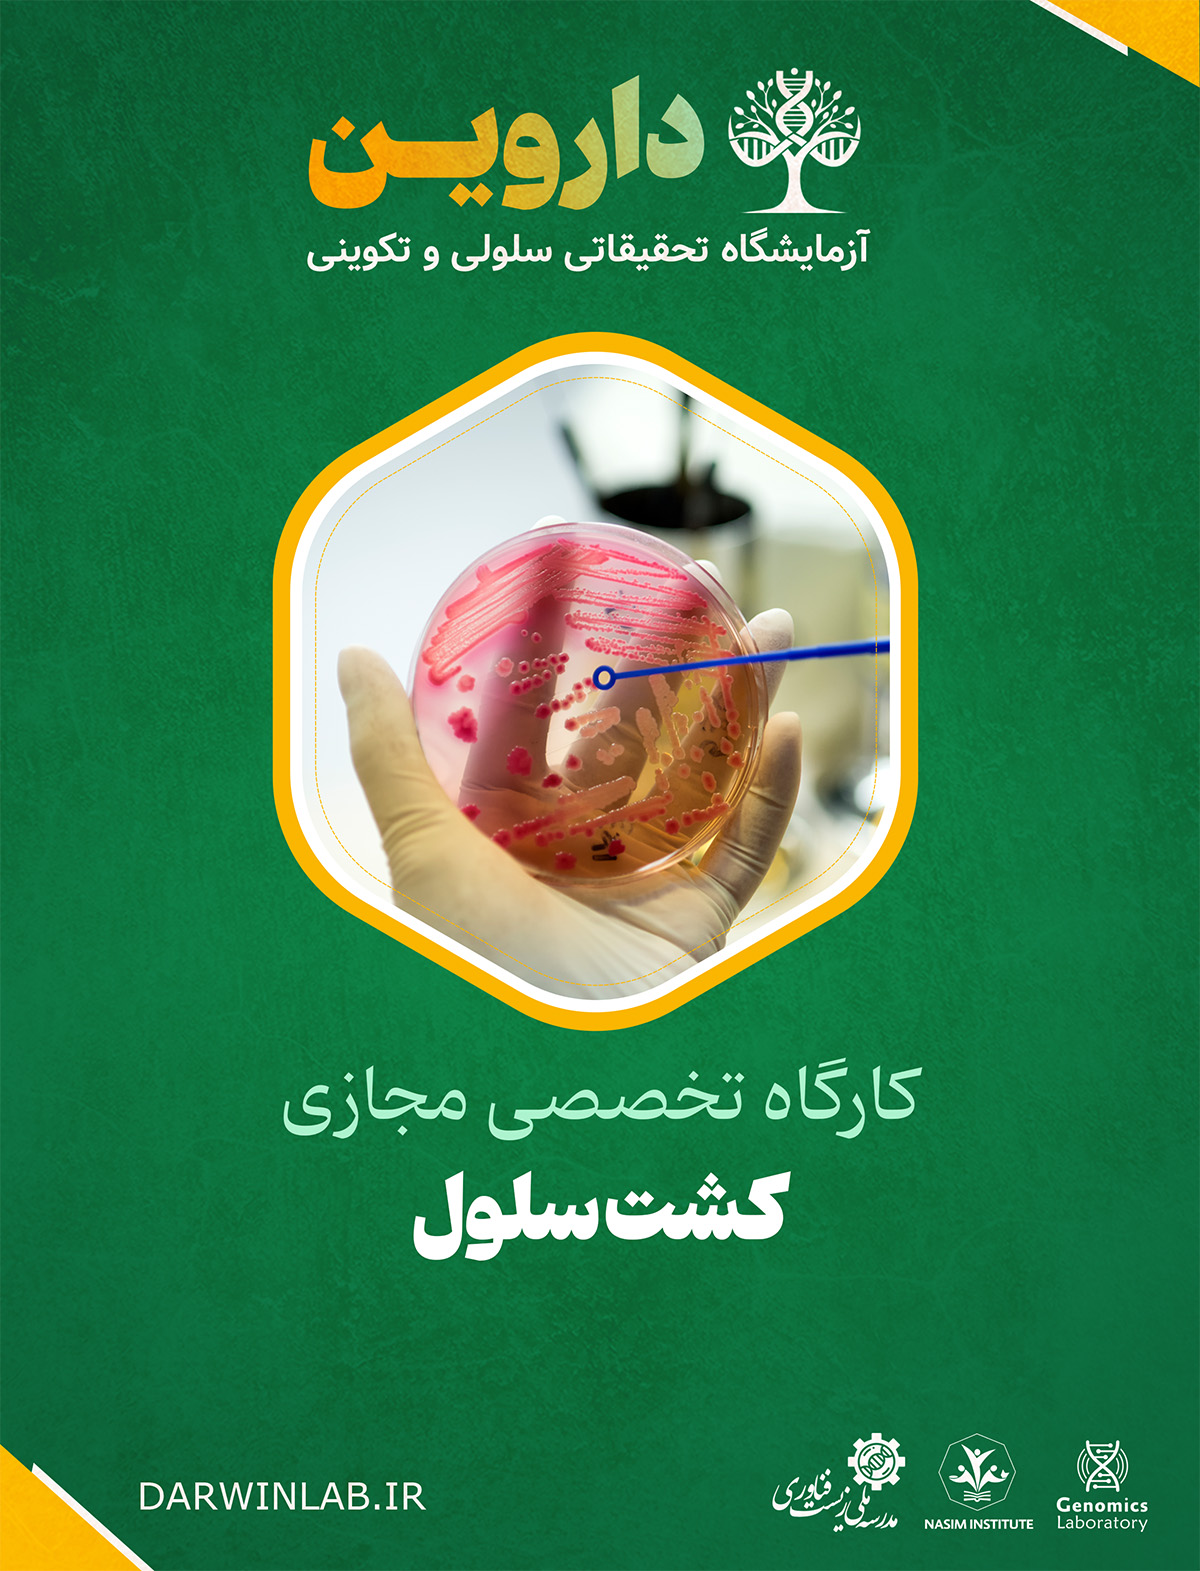
کشت سلول

آزمایشگاه تحقیقاتی داروین علوم زیستی، جانوری، گیاهی و سلولهای بنیادی
کارگاه کشت سلول
این کارگاه تخصصی، شما را با اصول و تکنیکهای اساسی کشت سلول آشنا میسازد. در این دوره، شما با روشهای استریل کار کردن در محیط آزمایشگاه، ذوب کردن سلولهای منجمد شده، شمارش سلولها، گسترش و کشت آنها و انجماد سلولها آشنا خواهید شد. این مهارتها برای پژوهش در زمینههای مختلف زیستشناسی سلولی، پزشکی بازساختی و تولید زیستداروها ضروری هستند.
textمهارتهای اکتسابی در کارگاه کشت سلول:
- تسلط بر تکنیکهای Aseptic Technique (روش استریل)
- توانایی انجام صحیح Thawing (ذوب کردن) سلولهای منجمد شده
- آشنایی با روشهای مختلف Counting (شمارش) سلولها
- مهارت در Expanding (گسترش و کشت) سلولها
- تسلط بر تکنیکهای Freezing (انجماد) سلولها
کاربردهای تخصصی کشت سلول:
- پژوهشهای زیستپزشکی: مطالعه مکانیسمهای بیماریها و غربالگری دارو
- پزشکی بازساختی: تولید سلولهای بنیادی و بافتهای مهندسی شده
- تولید زیستداروها: تولید آنتیبادیها، واکسنها و پروتئینهای درمانی
- آزمایشگاههای تشخیصی: کشت سلول برای تستهای ژنتیکی و سیتولوژی
- صنایع آرایشی و بهداشتی: تست محصولات بر روی مدلهای سلولی
نیاز بازار کار و فرصتهای شغلی در کشت سلول:
در سطح بینالملل:
تسلط بر تکنیکهای کشت سلول، یک مهارت بسیار پرتقاضا در شرکتهای بیوتکنولوژی، داروسازی و مراکز تحقیقاتی در سراسر جهان است. موقعیتهای شغلی مانند Cell Culture Specialist، Tissue Culture Technologist و Stem Cell Researcher از جمله فرصتهای شغلی این حوزه هستند.
در داخل ایران:
با توسعه مراکز سلولدرمانی و پزشکی بازساختی در ایران، تقاضا برای متخصصان کشت سلول در حال رشد است. این تخصص امکان اشتغال در مراکز تحقیقاتی، شرکتهای دانشبنیان فعال در حوزه زیستفناوری و آزمایشگاههای تخصصی را فراهم میکند.
آینده شغلی کشت سلول در ایران:
با سرمایهگذاریهای صورت گرفته در حوزه پزشکی بازساختی و سلولدرمانی، آینده این حرفه در ایران بسیار امیدوارکننده است. یک متخصص میتواند در مسیر مدیریت آزمایشگاه کشت سلول، توسعه پروتکلهای جدید کشت و مشاوره تخصصی پیشرفت کند.
آینده شغلی کشت سلول در خارج از ایران:
توسعه فناوریهای نوین در زمینه کشت سلولهای بنیادی، مهندسی بافت و پزشکی شخصیشده، زمینههای جدیدی برای پژوهش و اشتغال ایجاد کرده است. یک متخصص میتواند در شرکتهای پیشرو در زمینه تولید ارگانویدها و مدلهای بیماری فعالیت نماید.
نکات جالب و کاربردی:
- اولین کشت سلول موفق در سال ۱۹۰۷ توسط Ross Granville Harrison انجام شد
- خطوط سلولی HeLa که از سلولهای سرطان دهانه رحم هنریتا لاکس گرفته شده، از سال ۱۹۵۱ تاکنون در تحقیقات استفاده میشود
- تکنیکهای aseptic technique میتوانند میزان آلودگی کشت سلول را به کمتر از ۱٪ کاهش دهند
- سلولهای منجمد شده در نیتروژن مایع (-۱۹۶ درجه سانتیگراد) میتوانند برای دههها زنده بمانند
- کشت سلولهای بنیادی پرتوان القایی (iPSCs) انقلابی در پزشکی بازساختی ایجاد کرده است
سرفصلهای اصلی کارگاه کشت سلول:
- Aseptic Technique: آموزش کار در هود لامینار، ضدعفونی سطوح و استریل کردن ابزارها
- Thawing: آموزش روش صحیح ذوب کردن ویالهای سلولی منجمد شده
- Counting: آموزش استفاده از هموسیتومتر و اتوماتیک سل کانتر برای شمارش سلولها
- Expanding: آموزش ساب کالچر، تغذیه سلولها و کنترل رشد سلولی
- Freezing: آموزش روشهای انجماد سلولها و استفاده از cryoprotectants
این کارگاه، شما را با دانش و مهارتهای تخصصی لازم برای کار در آزمایشگاه کشت سلول مجهز میکند و فرصتهای شغلی متعددی در مراکز تحقیقاتی و شرکتهای زیستفناوری برای شما ایجاد خواهد کرد.
قوانین شرکت در کارگاه
محدودیتی در رشته و مقطع تحصیلی شرکت کننندگان وجود ندارد
امکان انصراف از ثبت نام و عودت وجه پرداختی تحت هیچ شرایط امکانپذیر نمی باشد
اجرای کارگاه تنها با استفاده از نرم افزار انلاین استودیو ویژه نسخه ویندوز (8 به بالا) امکان پذیر است
مدت مشاهده محتوای کارگاه از روز شروع 12 روز و غیر قابل تمدید است
جهت دانلود نرم افزار آنلاین استودیو اینجا کلیک نمایید